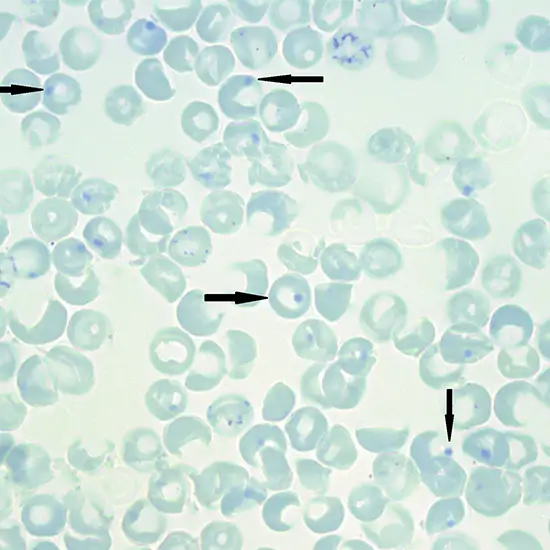
heinz bodies peripheral, blood

Book Heinz Bodies Peripheral Blood Appointment Online Near me at the best price in Delhi/NCR from Ganesh Diagnostic. NABL & NABH Accredited Diagnostic centre and Pathology lab in Delhi offering a wide range of Radiology & Pathology tests. Get Free Ambulance & Free Home Sample collection. 24X7 Hour Open. Call Now at 011-47-444-444 to Book your Heinz Bodies Peripheral Blood at 50% Discount.
Heinz Bodies are a group of damaged hemoglobin located on red blood cells. When hemoglobin becomes damaged, it can cause the red blood cells to stop working properly.
Heinz Bodies, Peripheral Blood Test detects the presence of Heinz bodies. The presence of Heinz bodies on a blood test indicates oxidative damage to the hemoglobin in red blood cells.
You need to give a blood sample from the vein in your arm for Heinz Bodies, Peripheral Blood Test.
The doctor may ask you for fasting and give you special instructions as per your medical condition. So, inform your doctor if you are taking any medications or have any medical conditions.
>>This is a simple blood test. So, no risk factors are involved.
The cost of Heinz Bodies, Peripheral Blood Test near me in Delhi ranges from INR 50 to INR 500.
| Test Type | Heinz Bodies Peripheral Blood |
| Includes | Heinz Bodies Peripheral Blood Test (Hematology) |
| Preparation | |
| Reporting | Within 24 hours* |
| Test Price |
₹ 65
|

Early check ups are always better than delayed ones. Safety, precaution & care is depicted from the several health checkups. Here, we present simple & comprehensive health packages for any kind of testing to ensure the early prescribed treatment to safeguard your health.